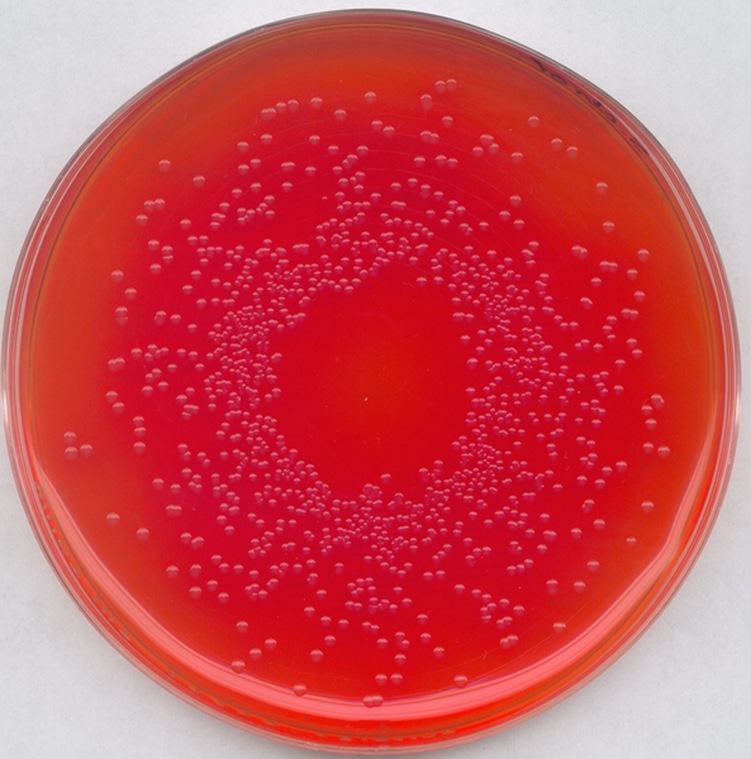
默克密理博 merck millipore 亮绿酚红乳糖蔗糖琼酯 1.07237.0500

酚红培养基

默克密理博merck甘露糖醇酚红培养基预制1.46023.0020
图片尺寸600x400
dmem培养基无糖无酚红bcm035500ml
图片尺寸519x671
biosharp bl309a m199液体培养基 含酚红 hepes 不含丙酮酸钠
图片尺寸600x600
宝林科在线商城
图片尺寸650x600
dmem高糖液体培养基,含酚红,hepes,不含丙酮酸钠
图片尺寸800x800
biosharp bl312a imdm液体培养基 含酚红 hepes 丙酮酸钠
图片尺寸600x600
盒 杭州赛洛进生物科技有限公司 商品详情胰酶细胞消化液 不含酚红
图片尺寸362x569
酚红葡萄糖肉汤(青岛海博)_其他细菌培养基_培养基_仪器试剂__食品
图片尺寸800x468
11095500btmemearles培养基含l-谷氨酰胺和酚红500ml c11095500bt 500
图片尺寸1280x1706
金黄色葡萄球菌对甘露醇盐酚红琼脂
图片尺寸1100x1100
rpmi 1640培养基 含酚红 原装进口life gibco
图片尺寸800x800
l-谷氨酰胺 酚红 丙酮酸钠本品为dmem高糖液体培养基dmem独特之处
图片尺寸2106x2106
c10010500bt gibco pbs
图片尺寸600x556
gibco:c11095500bt:mem:earles:培养基:含l-谷氨酰胺和酚红:500ml c1
图片尺寸1280x1706
即用型培养基
图片尺寸1600x806
vivacell-液体培养基-89350695-上海逍鹏生物科技有限公司
图片尺寸2000x1333
moocow(牧卡欧)leibovitzs l-15培养基 500ml(含酚红,d-半乳糖,l-谷
图片尺寸800x800
01b-hyclone 培养液sh30228.01b 500ml
图片尺寸750x750
加氯仿混匀后离心,其中一管在酚红的
图片尺寸1708x1676
默克密理博 merck millipore 亮绿酚红乳糖蔗糖琼酯 1.07237.0500
图片尺寸751x759